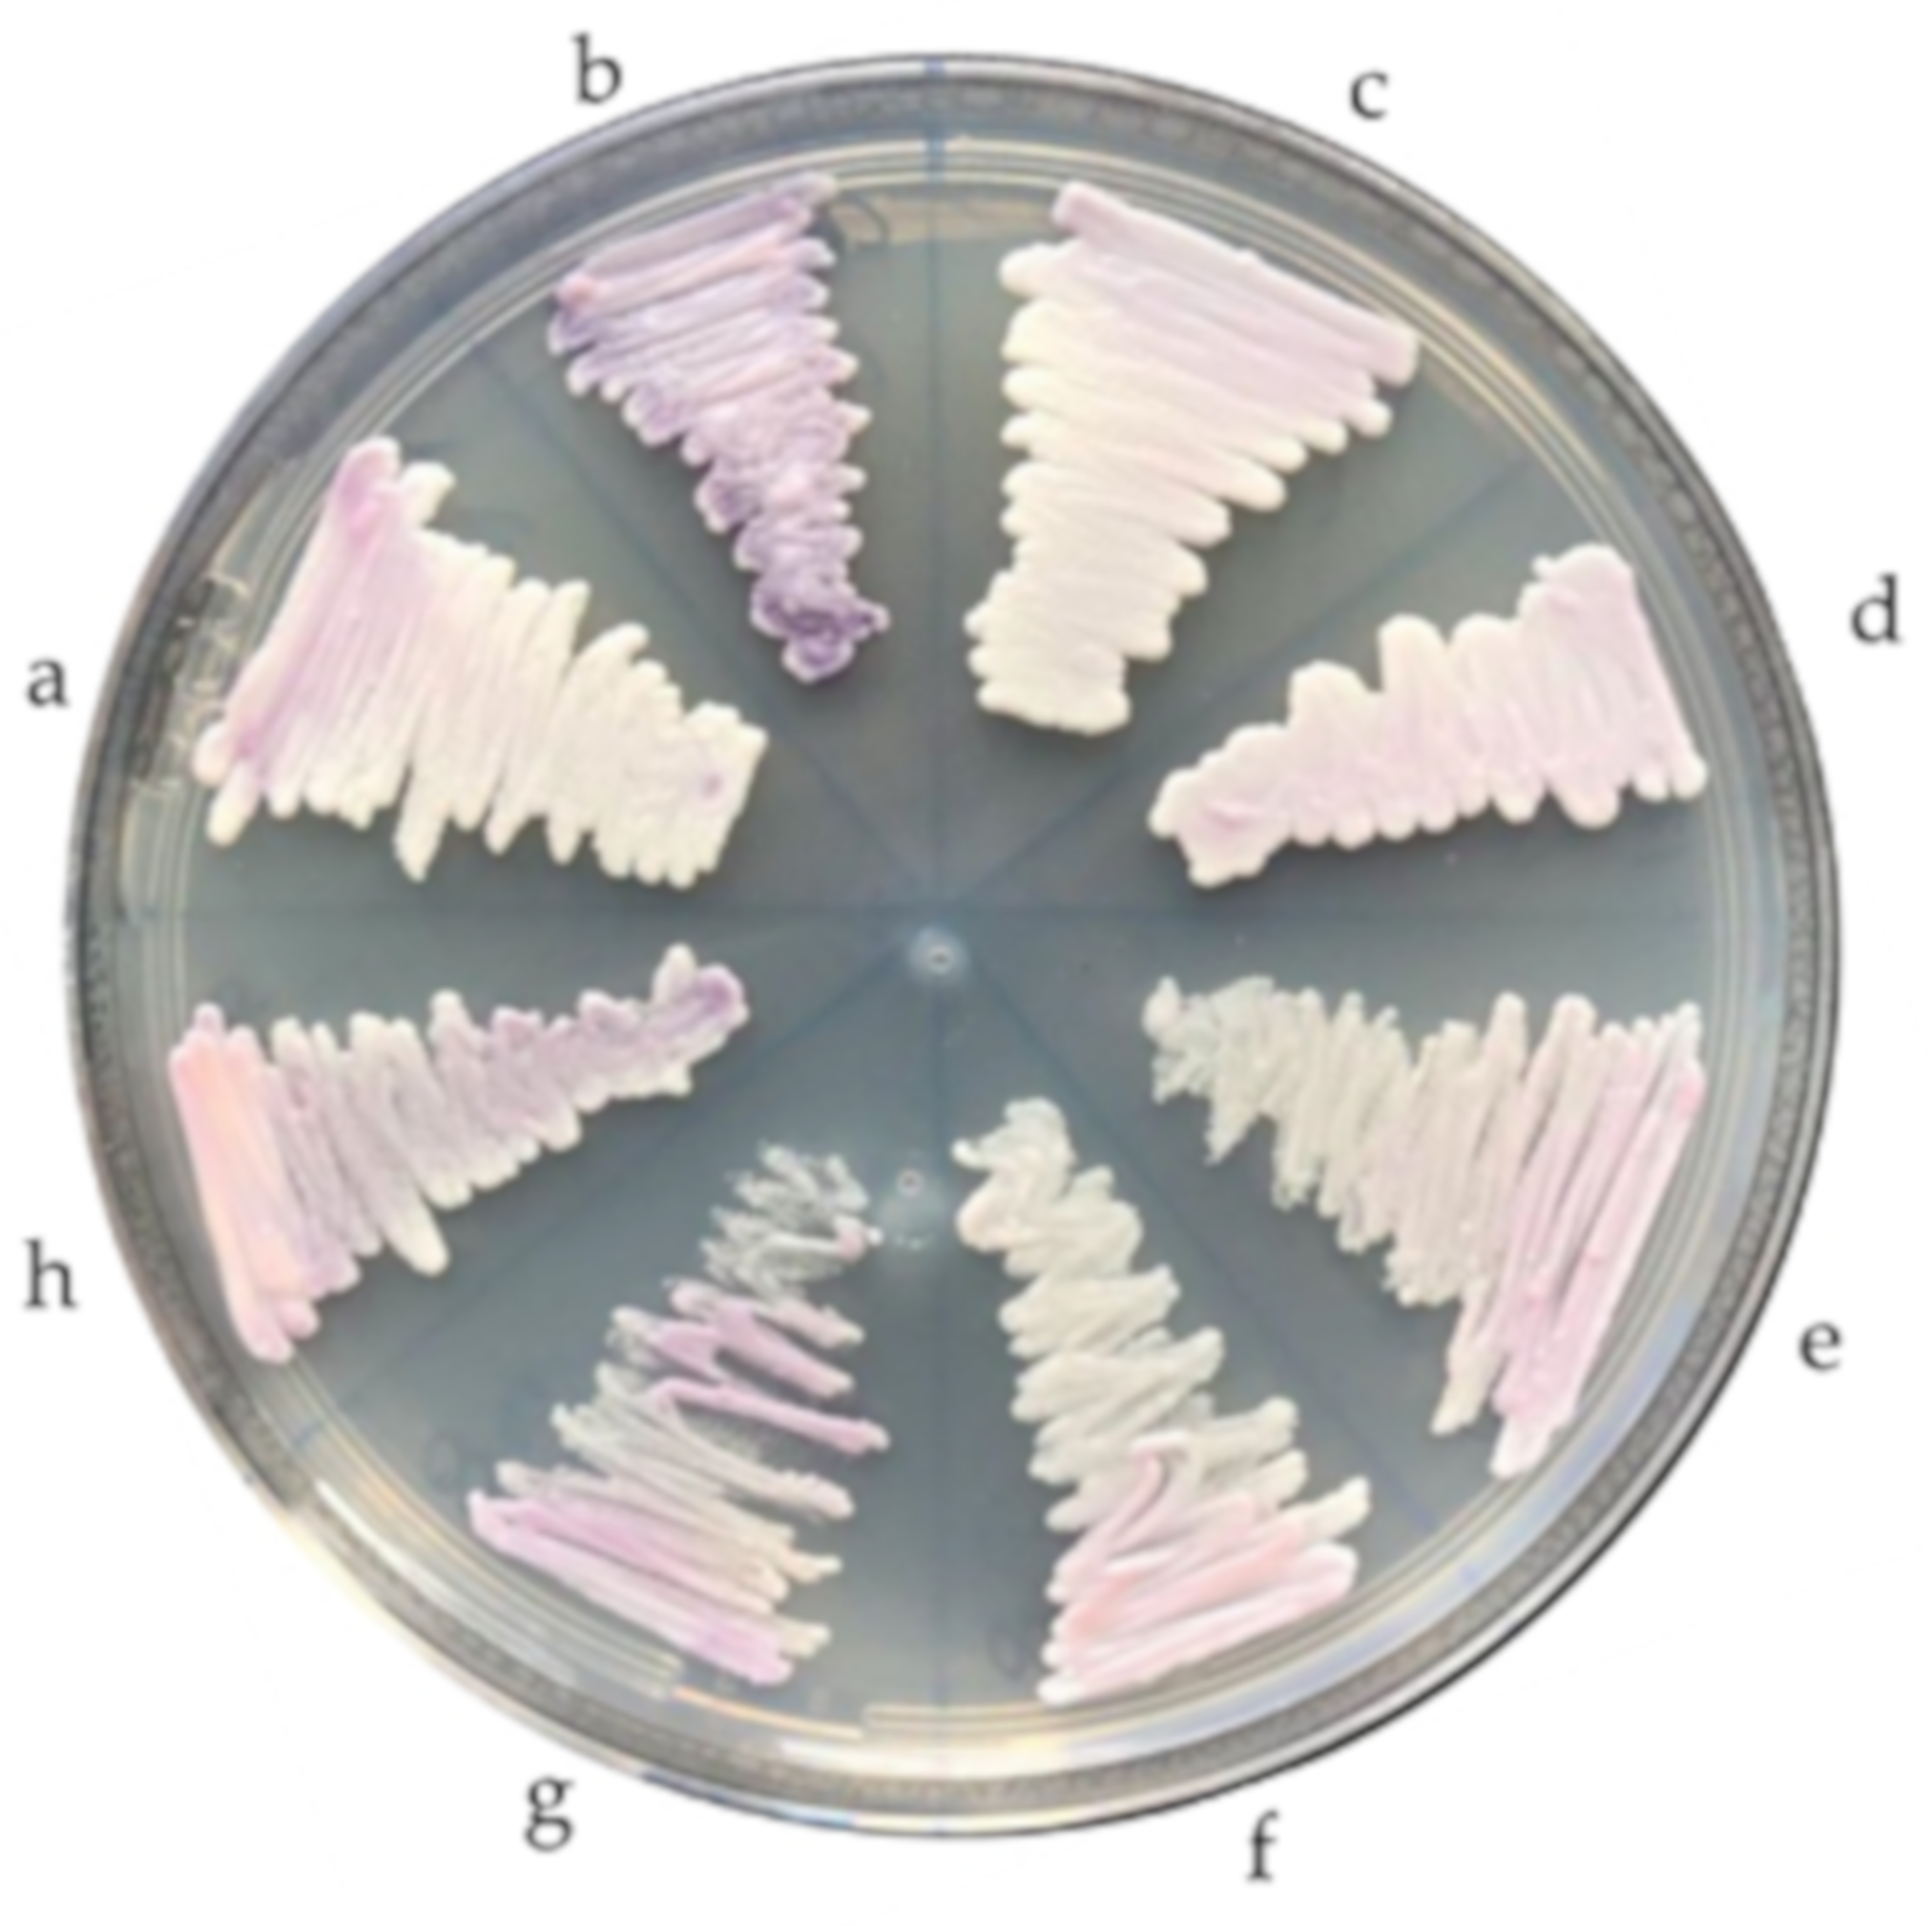
Jof 06 00374 g002

Candida duobushaemulonii: An Old But Unreported Pathogen
Abstract
1. Introduction
2. Materials and Methods
2.1. Fungal Isolates
2.2. Sample Preparation and DNA Extraction
2.3. PCR-Based Molecular Identification
2.4. ITS Region Sequencing and Species Identification
2.5. In Vitro Antifungal Susceptibility
2.6. Phenotypical Characterization
3. Results
3.1. Molecular Identification
3.2. Fungal Susceptibility
3.3. Phenotypic Characteristics
4. Discussion
5. Conclusions
Author Contributions
Funding
Acknowledgments
Conflicts of Interest
References
- Brandt, M.E.; Lockhart, S.R. Recent taxonomic developments with Candida and other opportunistic yeasts. Curr. Fungal Infect. Rep. 2012, 6, 170–177. [Google Scholar] [CrossRef] [PubMed]
- Lavarde, V.; Daniel, F.; Saez, H.; Arnold, M.; Faguer, B. Peritonite mycosique a Torulopsis haemulonii. Bull. Soc. Fr. Mycol. Med. 1984, 13, 173–176. [Google Scholar]
- Lehmann, P.F.; Wu, L.C.; Pruitt, W.R.; Meyer, S.A.; Ahearn, D.G. Unrelatedness of groups of yeasts within the Candida haemulonii complex. J. Clin. Microbiol. 1993, 31, 1683–1687. [Google Scholar] [CrossRef] [PubMed]
- Cendejas-Bueno, E.; Kolecka, A.; Alastruey-Izquierdo, A.; Theelen, B.; Groenewald, M.; Kostrzewa, M.; Cuenca-Estrella, M.; Gómez-López, A.; Boekhout, T. Reclassification of the Candida haemulonii complex as Candida haemulonii (C. haemulonii group I), C. duobushaemulonii sp. nov. (C. haemulonii group II), and C. haemulonii varvulnera var. nov.: Three multiresistant human pathogenic yeasts. J. Clin. Microbiol. 2012, 50, 3641–3651. [Google Scholar] [CrossRef] [PubMed]
- Sugita, T.; Takashima, M.; Poonwan, N.; Mekha, N. Candida pseudohaemulonii Sp. Nov., an amphotericin B-and azole-resistant yeast species, isolated from the blood of a patient from Thailand. Microbiol. Immunol. 2006, 50, 469–473. [Google Scholar] [CrossRef] [PubMed]
- Satoh, K.; Makimura, K.; Hasumi, Y.; Nishiyama, Y.; Uchida, K.; Yamaguchi, H. Candida auris sp. nov., a novel ascomycetous yeast isolated from the external ear canal of an inpatient in a Japanese hospital. Microbiol. Immunol. 2009, 53, 41–44. [Google Scholar] [CrossRef]
- González, G.M.; Treviño-Rangel, R.J.; Palma-Nicolás, J.P.; Martínez, C.; González, J.G.; Ayala, J.; Caballero, A.; Morfín-Otero, R.; Rodríguez-Noriega, E.; Velarde, F.; et al. Species distribution and antifungal susceptibility of bloodstream fungal isolates in paediatric patients in Mexico: A nationwide surveillance study. J. Antimicrob. Chemother. 2013, 68, 2847–2851. [Google Scholar] [CrossRef]
- Arendrup, M.C.; Dzajic, E.; Jensen, R.H.; Johansen, H.K.; Kjaeldgaard, P.; Knudsen, J.D.; Kristensen, L.; Leitz, C.; Lemming, L.E.; Nielsen, L.; et al. Epidemiological changes with potential implication for antifungal prescription recommendations for fungaemia: Data from a nationwide fungaemia surveillance programme. Clin. Microbiol. Infect. 2013, 19, E343–E353. [Google Scholar] [CrossRef]
- Guinea, J.; Zaragoza, Ó.; Escribano, P.; Martín-Mazuelos, E.; Pemán, J.; Sánchez-Reu, S.F.; Cuenca-Estrella, M. CANDIPOP Project, GEIH-GEMICOMED (SEIMC), and REIPI. Molecular identification and antifungal susceptibility of yeast isolates causing fungemia collected in a population-based study in Spain in 2010 and 2011. Antimicrob. Agents Chemother. 2014, 58, 1529–1537. [Google Scholar] [CrossRef]
- Ramos, L.S.; Figueiredo-Carvalho, M.H.; Barbedo, L.S.; Ziccardi, M.; Chaves, A.L.; Zancopé-Oliveira, R.M.; Pinto, M.R.; Sgarbi, D.B.; Dornelas-Ribeiro, M.; Branquinha, M.H.; et al. Candida haemulonii complex: Species identification and antifungal susceptibility profiles of clinical isolates from Brazil. J. Antimicrob. Chemother. 2015, 70, 111–115. [Google Scholar] [CrossRef]
- Boatto, H.F.; Cavalcanti, S.D.; Del Negro, G.M.; Girão, M.J.; Francisco, E.C.; Ishida, K.; Gompertz, O.F. Candida duobushaemulonii: An emerging rare pathogenic yeast isolated from recurrent vulvovaginal candidiasis in Brazil. Mem. Inst. Oswaldo Cruz 2016, 111, 407–410. [Google Scholar] [CrossRef] [PubMed]
- De Almeida, J.N., Jr.; Assy, J.G.; Levin, A.S.; Del Negro, G.M.; Giudice, M.C.; Tringoni, M.P.; Thomaz, D.Y.; Motta, A.L.; Abdala, E.; Pierroti, L.C.; et al. Candida haemulonii complex species, Brazil, January 2010-March 2015. Emerg. Infect. Dis. 2016, 22, 561–563. [Google Scholar] [CrossRef] [PubMed]
- Frías-De-León, M.G.; Martínez-Herrera, E.; Acosta-Altamirano, G.; Arenas, R.; Rodríguez-Cerdeira, C. Superficial candidosis by Candida duobushaemulonii: An emerging microorganism. Infect. Genet. Evol. 2019, 75, 103960. [Google Scholar] [CrossRef] [PubMed]
- Osei Sekyere, J. Candida auris: A systematic review and meta-analysis of current updates on an emerging multidrug-resistant pathogen. Microbiologyopen 2019, e00901. [Google Scholar] [CrossRef]
- Cortegiani, A.; Misseri, G.; Fasciana, T.; Giammanco, A.; Giarratano, A.; Chowdhary, A. Epidemiology, clinical characteristics, resistance, and treatment of infections by Candida auris. J. Intensive Care 2018, 6, 69. [Google Scholar] [CrossRef]
- Kim, M.N.; Shin, J.H.; Sung, H.; Lee, K.; Kim, E.C.; Ryoo, N.; Lee, J.S.; Jung, S.I.; Park, K.H.; Kee, S.J.; et al. Candida haemulonii and closely related species at 5 university hospitals in Korea: Identification, antifungal susceptibility, and clinical features. Clin. Infect. Dis. 2009, 48, e57–e61. [Google Scholar] [CrossRef]
- Ruan, S.Y.; Kuo, Y.W.; Huang, C.T.; Hsiue, H.C.; Hsueh, P.R. Infections due to Candida haemulonii: Species identification, antifungal susceptibility and outcomes. Int. J. Antimicrob. Agents 2010, 35, 85–88. [Google Scholar] [CrossRef]
- Kathuria, S.; Singh, P.K.; Sharma, C.; Prakash, A.; Masih, A.; Kumar, A.; Meis, J.F.; Chowdhary, A. Multidrug-resistant Candida auris misidentified as Candida haemulonii: Characterization by Matrix-Assisted Laser Desorption Ionization-Time of Flight Mass Spectrometry and DNA sequencing and its antifungal susceptibility profile variability by Vitek 2, CLSI broth microdilution, and Etest method. J. Clin. Microbiol. 2015, 53, 1823–1830. [Google Scholar] [CrossRef]
- Ben-Ami, R.; Berman, J.; Novikov, A.; Bash, E.; Shachor-Meyouhas, Y.; Zakin, S.; Maor, Y.; Tarabia, J.; Schechner, V.; Adler, A.; et al. Multidrug-Resistant Candida haemulonii and C. auris, Tel Aviv, Israel. Emerg. Infect. Dis. 2017, 23, 195–203. [Google Scholar] [CrossRef]
- Muro, M.D.; Motta, F.d.A.; Burger, M.; Melo, A.S.; Dalla-Costa, L.M. Echinocandin resistance in two Candida haemulonii isolates from pediatric patients. J. Clin. Microbiol. 2012, 50, 3783–3785. [Google Scholar] [CrossRef]
- Kumar, A.; Prakash, A.; Singh, A.; Kumar, H.; Hagen, F.; Meis, J.F.; Chowdhary, A. Candida haemulonii species complex: An emerging species in India and its genetic diversity assessed with multilocus sequence and amplified fragment-length polymorphism analyses. Emerg. Microves. Infect. 2012, 5, e49. [Google Scholar] [CrossRef] [PubMed]
- Hou, X.; Xiao, M.; Chen, S.C.; Wang, H.; Cheng, J.W.; Chen, X.X.; Xu, Z.P.; Fan, X.; Kong, F.; Xu, Y.C. Identification and antifungal susceptibility profiles of Candida haemulonii species complex clinical isolates from a multicenter study in China. J. Clin. Microbiol. 2016, 54, 2676–2680. [Google Scholar] [CrossRef] [PubMed]
- Desnos-Ollivier, M.; Ragon, M.; Robert, V.; Raoux, D.; Gantier, J.C.; Dromer, F. Debaryomyces hansenii (Candida famata), a rare human fungal pathogen often misidentified as Pichia guilliermondii (Candida guilliermondii). J. Clin. Microbiol. 2008, 46, 3237–3242. [Google Scholar] [CrossRef] [PubMed]
- Navalkele, B.D.; Revankar, S.; Chandrasekar, P. Candida auris: A worrisome, globally emerging pathogen. Expert Rev. AntiInfect. Ther. 2017, 15, 819–827. [Google Scholar] [CrossRef] [PubMed]
- Sarma, S.; Upadhyay, S. Current perspective on emergence, diagnosis and drug resistance in Candida auris. Infect. Drug Resist. 2017, 10, 155–165. [Google Scholar] [CrossRef] [PubMed]
- Marcos-Arias, C.; Mateo, E.; Jurado-Martín, I.; Pena-Fernández, N.; Cantón, E.; Pemán, J.; Quindós, G.; Eraso, E. Utility of two PCR-RFLP-based techniques for identification of Candida parapsilosis complex blood isolates. Mycoses 2020, 63, 461–470. [Google Scholar] [CrossRef]
- Kordalewska, M.; Zhao, Y.; Lockhart, S.R.; Chowdhary, A.; Berrio, I.; Perlin, D.S. Rapid and accurate molecular identification of the emerging multidrug-resistant pathogen Candida auris. J. Clin. Microbiol. 2017, 55, 2445–2452. [Google Scholar] [CrossRef]
- Martínez-Murcia, A.; Navarro, A.; Bru, G.; Chowdhary, A.; Hagen, F.; Meis, J.F. Internal validation of GPS MONODOSE CanAur dtec-qPCR kit following the UNE/EN ISO/IEC 17025:2005 for detection of the emerging yeast Candida auris. Mycoses 2018, 61, 877–884. [Google Scholar] [CrossRef]
- Sexton, D.J.; Kordalewska, M.; Bentz, M.L.; Welsh, R.M.; Perlin, D.S.; Litvintseva, A.P. Direct detection of emergent fungal pathogen Candida auris in clinical skin swabs by SYBR Green-based quantitative PCR assay. J. Clin. Microbiol. 2018, 56, e01337-18. [Google Scholar] [CrossRef]
- Ahmad, A.; Spencer, J.E.; Lockhart, S.R.; Singleton, S.; Petway, D.J.; Bagarozzi, D.A., Jr.; Herzegh, O.T. A high-throughput and rapid method for accurate identification of emerging multidrug-resistant Candida auris. Mycoses 2019, 62, 513–518. [Google Scholar] [CrossRef]
- Ruiz-Gaitán, A.C.; Fernández-Pereira, J.; Valentin, E.; Tormo-Mas, M.A.; Eraso, E.; Pemán, J.; de Groot, P.W.J. Molecular identification of Candida auris by PCR amplification of species-specific GPI protein-encoding genes. Int. J. Med. Microbiol. 2018, 308, 812–818. [Google Scholar] [CrossRef] [PubMed]
- Arastehfar, A.; Fang, W.; Badali, H.; Vaezi, A.; Jiang, W.; Liao, W.; Pan, W.; Hagen, F.; Boekhout, T. Low-cost tetraplex PCR for the global spreading multi-drug resistant fungus, Candida auris and its phylogenetic relatives. Front. Microbiol. 2018, 9, 1119. [Google Scholar] [CrossRef] [PubMed]
- Arastehfar, A.; Fang, W.; Daneshnia, F.; Al-Hatmi, A.M.; Liao, W.; Pan, W.; Khan, Z.; Ahmad, S.; Rosam, K.; Lackner, M.; et al. Novel multiplex real-time quantitative PCR detecting system approach for direct detection of Candida auris and its relatives in spiked serum samples. Future Microbiol. 2019, 14, 33–45. [Google Scholar] [CrossRef] [PubMed]
- Theill, L.; Dudiuk, C.; Morales-Lopez, S.; Berrio, I.; Rodríguez, J.Y.; Marin, A.; Gamarra, S.; Garcia-Effron, G. Single-tube classical PCR for Candida auris and Candida haemulonii identification. Rev. Iberoam. Micol. 2018, 35, 110–112. [Google Scholar] [CrossRef] [PubMed]
- Ruiz Gaitán, A.C.; Moret, A.; López Hontangas, J.L.; Molina, J.M.; Aleixandre López, A.I.; Cabezas, A.H.; Mollar Maseres, J.; Arcas, R.C.; Gómez Ruiz, M.D.; Chiveli, M.Á.; et al. Nosocomial fungemia by Candida auris: First four reported cases in continental Europe. Rev. Iberoam. Micol. 2017, 34, 23–27. [Google Scholar] [CrossRef] [PubMed]
- White, T.J.; Bruns, T.D.; Lee, S.B.; Taylor, J.W. Amplification and Direct Sequencing of Fungal Ribosomal RNA Genes for Phylogenetics PCR—Protocols and Applications—A Laboratory Manual; Academic Press: Cambridge, MA, USA, 1990; pp. 315–322. [Google Scholar]
- Kumar, A.; Sachu, A.; Mohan, K.; Vinod, V.; Dinesh, K.; Karim, S. Simple low cost differentiation of Candida auris from Candida haemulonii complex using CHROMagar Candida medium supplemented with Pal’s medium. Rev. Iberoam. Micol. 2017, 34, 109–111. [Google Scholar] [CrossRef] [PubMed]
- Quindós, G.; Marcos-Arias, C.; San-Millán, R.; Mateo, E.; Eraso, E. The continuous changes in the aetiology and epidemiology of invasive candidiasis: From familiar Candida albicans to multiresistant Candida auris. Int. Microbiol. 2018, 21, 107–119. [Google Scholar] [CrossRef] [PubMed]
- Pfaller, M.A.; Diekema, D.J.; Gibbs, D.L.; Newell, V.A.; Ellis, D.; Tullio, V.; Rodloff, A.; Fu, W.; Ling, T.A. Global Antifungal Surveillance Group. Results from the ARTEMIS DISK global antifungal surveillance study, 1997 to 2007: A 10.5-year analysis of susceptibilities of Candida species to fluconazole and voriconazole as determined by CLSI standardized disk diffusion. J. Clin. Microbiol. 2010, 48, 1366–1377. [Google Scholar] [CrossRef]
- Oberoi, J.K.; Wattal, C.; Goel, N.; Raveendran, R.; Datta, S.; Prasad, K. Non-albicans Candida species in blood stream infections in a tertiary care hospital at New Delhi, India. Indian J. Med. Res. 2012, 136, 997–1003. [Google Scholar]
- Gargeya, I.B.; Pruitt, W.R.; Meyer, S.A.; Ahearn, D.G. Candida haemulonii from clinical specimens in the USA. J. Med. Vet. Mycol. 1991, 29, 335–338. [Google Scholar] [CrossRef]
- Gade, L.; Muñoz, J.F.; Sheth, M.; Wagner, D.; Berkow, E.L.; Forsberg, K.; Jackson, B.R.; Ramos-Castro, R.; Escandón, P.; Dolande, M.; et al. Understanding the emergence of multidrug-resistant Candida: Using whole-genome sequencing to describe the population structure of Candida haemulonii species complex. Front. Genet. 2020, 11, 554. [Google Scholar] [CrossRef] [PubMed]
- Silva, L.N.; Oliveira, S.S.C.; Magalhães, L.B.; Andrade Neto, V.V.; Torres-Santos, E.C.; Carvalho, M.D.C.; Pereira, M.D.; Branquinha, M.H.; Santos, A.L.S. Unmasking the Amphotericin B resistance mechanisms in Candida haemulonii species complex. ACS Infect. Dis. 2020, 6, 1273–1282. [Google Scholar] [CrossRef] [PubMed]

| Primer Name | Primer Sequence (5′ 3′) | Amplicon Size (bp) | Reference |
|---|---|---|---|
| 05701_F | GCAGCACTCGTGAGAGAACT | 193 | [35] |
| 05701_R | GGCTGGTTCTCCTGCTCATT | ||
| RDN58_F | GGATCTCTTGGTTCTCGC | 134 | |
| RDN58_R | CGCTCAAACAGGCATGC | ||
| Uni-F | GAACGCACATTGCGCCTTGG | [32] | |
| Au-R | TCCAAAGGACTTGCCTGCT | 331 | |
| Du-R | GTAGACTTCGCTGCGGATATGTTA | 115 | |
| Ha-R | ATTGCGCCAGCATCCTTATTG | 696 | |
| Ps-R | GCACCCGATGCTGACAGTCTAC | 576 |
| Isolate Number | Year of Isolation | Source of Isolation | Previous Identification (API ID®32C) | C. auris-Specific PCR | C. haemulonii Complex-Tetraplex PCR | ITS Sequencing | MIC (μg/mL)/Susceptibility Profile | |||||||||
|---|---|---|---|---|---|---|---|---|---|---|---|---|---|---|---|---|
| C. auris- Specific Band | Quality Control Band | AND | MCF | CAS | POS | VOR | ITR | FLZ | AB | 5FL | ||||||
| 00-093 | 2000 | Maxilary sinus | C. haemulonii | - | + | C. haemulonii | C. haemulonii | 0.125 | 0.06 | 0.25 | 0.25 | 0.25 | 0.5 RS | 16 RS | 4 RS | <0.06 |
| 00-094 | 2000 | Homograft liquid | C. haemulonii | - | + | C. haemulonii | C. haemulonii | 0.03 | 0.06 | 0.125 | 0.25 | 0.25 | 0.5 RS | 16 RS | 2 RS | <0.06 |
| 00-095 | 2000 | Adenophlegmon liquid | C. haemulonii | - | + | C. haemulonii | C. haemulonii | 0.125 | 0.125 | 0.25 | 0.5 | 0.25 | 0.5 RS | 16 RS | 4 RS | <0.06 |
| 00-096 | 2000 | Bronchoalveolar lavage | C. haemulonii | - | + | C. haemulonii | C. haemulonii | 0.125 | 0.125 | 0.25 | 0.25 | 0.5 | 0.5 RS | 16 RS | 4 RS | <0.06 |
| 00-097 | 2000 | Corneal abscess | C. haemulonii | - | + | C. haemulonii | C. haemulonii | 0.125 | 0.125 | 0.25 | 0.25 | 0.5 | 0.5 RS | 64 RS | >8 RS | <0.06 |
| 00-180 | 2000 | Catheter | C. haemulonii | - | + | C. haemulonii | C. haemulonii | 0.125 | 0.125 | 0.25 | 0.5 | 1 | 1 RS | 64 RS | >8 RS | 0.125 |
| 00-181 | 2000 | Peritoneal fluid | C. haemulonii | - | + | C. haemulonii | C. haemulonii | 0.125 | 0.125 | 0.25 | 0.25 | 0.5 | 0.5 RS | 16 RS | 1 | <0.06 |
| 00-182 | 2000 | Mouth | C. haemulonii | - | + | C. haemulonii | C. haemulonii | 0.06 | 0.125 | 0.25 | 0.5 | 0.5 | 1 RS | 32 RS | 4 RS | <0.06 |
| 96-013 | 1996 | Toe nail | C. intermedia | - | + | C. duobushaemulonii | C. duobushaemulonii | 0.125 | 0.06 | 0.06 | 0.25 | 0.25 | 0.5 RS | 32 RS | 1 | <0.06 |
| 19-038 | - | + | C. duobushaemulonii | C. duobushaemulonii | 0.25 | 0.06 | 0.03 | 0.03 | 0.03 | 0.125 | 2 | 1 | <0.06 | |||
| 17-213 | 2017 | Blood | C. auris | + | C. auris | C. auris | 0.125 | 0.06 | 0.125 | 0.06 | 1 | 0.25 RS | >256 RS | 0.5 | <0.06 | |
| 17-257 | 2017 | Blood | C. auris | + | C. auris | C. auris | 0.125 | 0.06 | 0.125 | 0.125 | 2 RS | 0.25 RS | >256 RS | 1 | <0.06 | |
| CBS 10004 | - | + | C. pseudohaemulonii | C. pseudohaemulonii | 0.125 | 0.06 | 0.06 | 0.015 | 0.03 | 0.03 | 2 | 0.125 | <0.06 | |||
Publisher’s Note: MDPI stays neutral with regard to jurisdictional claims in published maps and institutional affiliations. |
© 2020 by the authors. Licensee MDPI, Basel, Switzerland. This article is an open access article distributed under the terms and conditions of the Creative Commons Attribution (CC BY) license (http://creativecommons.org/licenses/by/4.0/).
Share and Cite
Jurado-Martín, I.; Marcos-Arias, C.; Tamayo, E.; Guridi, A.; de Groot, P.W.J.; Quindós, G.; Eraso, E. Candida duobushaemulonii: An Old But Unreported Pathogen. J. Fungi 2020, 6, 374. https://doi.org/10.3390/jof6040374
Jurado-Martín I, Marcos-Arias C, Tamayo E, Guridi A, de Groot PWJ, Quindós G, Eraso E. Candida duobushaemulonii: An Old But Unreported Pathogen. Journal of Fungi. 2020; 6(4):374. https://doi.org/10.3390/jof6040374
Chicago/Turabian StyleJurado-Martín, Irene, Cristina Marcos-Arias, Esther Tamayo, Andrea Guridi, Piet W. J. de Groot, Guillermo Quindós, and Elena Eraso. 2020. "Candida duobushaemulonii: An Old But Unreported Pathogen" Journal of Fungi 6, no. 4: 374. https://doi.org/10.3390/jof6040374
APA StyleJurado-Martín, I., Marcos-Arias, C., Tamayo, E., Guridi, A., de Groot, P. W. J., Quindós, G., & Eraso, E. (2020). Candida duobushaemulonii: An Old But Unreported Pathogen. Journal of Fungi, 6(4), 374. https://doi.org/10.3390/jof6040374

